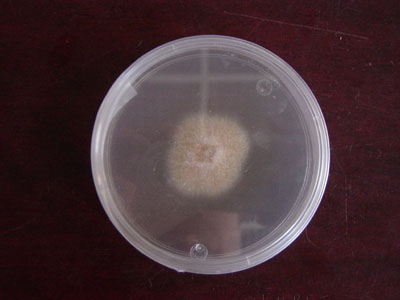

Evalúan microorganismos nativos de Sinaloa que funcionen como bioprotectores ante patógenos del cultivo de maíz
Investigadores de Sinaloa trabajan en la obtención de un producto agrobiológico que aumente en el suelo el número de las poblaciones de aquellos microorganismos que pueden controlar el crecimiento y proliferación del hongo fitopatógeno Fusarium en el cultivo de maíz.
Avances de resultados del proyecto Obtención y evaluación de un banco de germoplasma de microorganismos nativos de Sinaloa asociados a maíz para desarrollar bioprotectores para el control de Fusarium, apoyado por Fundación Produce Sinaloa, A.C., indican que hasta mayo de 2009 se cuenta con una colección de 5 mil microorganismos procariotas (bacterias) cultivables de suelos asociados a maíz.
Se espera que para 2013 se posea un banco de germoplasma inventariado de 10 mil microorganismos nativos de Sinaloa, que muestren capacidad de frenar el crecimiento y proliferación del patógeno en maíz, así como desarrollar un sistema automatizado para el escrutinio masivo de microorganismos antagonistas, que pudiera ser empleado en muchos otros sistemas producto de importancia estatal y nacional.
Actualidad con límites
Aunque en la actualidad se emplean agentes bioprotectores, en muchos casos su aplicación (hasta cierto punto empírica), para el control de enfermedades en cultivos como el maíz, no termina en éxito.
Una de las principales razones de esto es porque los microorganismos que se emplean no son nativos de la región donde se aplican.
Laboratorio para tecnología de punta
Este proyecto también permitirá el establecimiento de un laboratorio automatizado que posibilite emplear tecnología de punta para realizar un escrutinio rápido de la colección de microorganismos para el desarrollo de bioprotectores, no sólo para el control de Fusarium sino para cualquier otro hongo fitopatógeno y no limitado a maíz sino con potencial de impacto a otros cultivos de importancia económica.
Este laboratorio instalado con la plataforma robótica no se limita a realizar bioensayos de antagonismo sino también puede ser utilizado para monitorear la colección de microorganismos para otros potenciales usos biotecnológicos e incluso permite agilizar el diagnóstico de fitopatógenos y enfermedades por técnicas moleculares.
Hasta mayo de 2009 está instalado y puesto en marcha un laboratorio de robótica en el Centro Interdisciplinario de Investigación para el Desarrollo Integral Regional, Sinaloa, destinado a la evaluación de los microorganismos de la colección en cuanto a su capacidad bioprotectora contra el ataque de Fusarium in vitro y a nivel de planta.
Con información de Ignacio Eduardo Maldonado Mendoza, integrante del Centro Interdisciplinario de Investigación para el Desarrollo Integral Regional.
Impacto del proyecto en México
A pesar de la importancia que reviste la producción de maíz grano en México (con más de 8 millones de hectáreas sembradas en el país, con un valor de producción de 54 mil 418 millones de pesos), hasta 2009 no existe un esfuerzo tan importante como el presentado en el proyecto Obtención y evaluación de un banco de germoplasma de microorganismos nativos de Sinaloa asociados a maíz para desarrollar bioprotectores para el control de Fusarium.
Las pérdidas en superficie sembrada en el país fueron de más de 784 mil hectáreas en 2007 y aunque no se poseen datos exactos del porcentaje de éstas que fueron causadas por enfermedades, si se consideran que fueron 10 ó 20% significaría una afectación de 78 mil 400 ó 115 mil 680 hectáreas, respectivamente.
Esto señala la magnitud del impacto que tiene la creación de este tipo de herramientas tecnológicas, que pueden ser empleadas para la protección de un sistema producto tan importante para el país, como es el maíz.
![]() | ![]() |
![]() | ![]() |
Evalúan microorganismos nativos de Sinaloa que funcionen como bioprotectores ante patógenos del cultivo de maíz